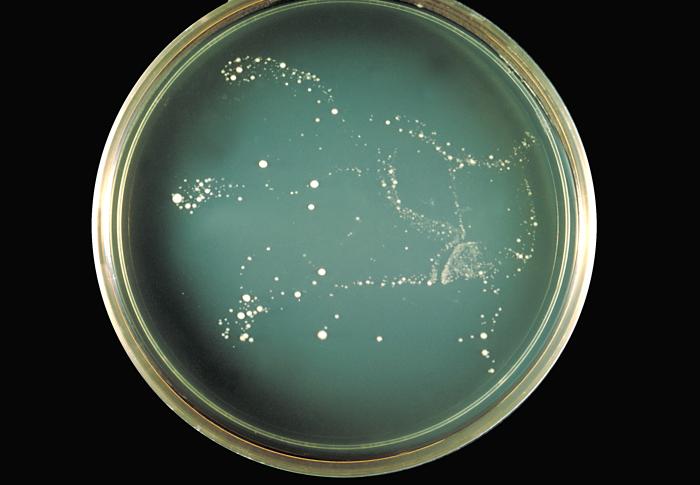
C. neoformans var. neoformans. CDC Public Health Image Library (PHIL).&nbsp;

Cryptococcus neoformans var. neoformans es un hongo levaduriforme perteneciente al filo Basidiomycota. Las células, de 4-6 micras (µm) de tamaño, son esféricas o elipsoides y están rodeadas de una cápsula polisacarídica gruesa que aumenta de tamaño hasta los 25 µm.
Se encuentra en forma de levadura, tanto en el medio ambiente como en el huésped durante la infección.
La forma teleomorfa, perfecta o micelial, se denomina Filobasidiella neoformans var. neoformans. Esta forma sólo ha podido encontrarse en el laboratorio bajo ciertas condiciones.
Las colonias pueden crecer a 37ºC y tienen un aspecto mucoso, típico de las cepas encapsuladas.
Aunque existen más de 30 especies de Cryptococcus, la mayoría de las infecciones en humanos son causadas por C. neoformans y C. gattii. Existen cuatro tipos en función de los antígenos capsulares (A, B, C, D). C. neoformans comprende los serotipos A y D, y se divide en dos variedades: C. neoformans var. grubii (serotipo A) y C. neoformans var. neoformans (serotipo D) (8).
Viabilidad, propagación y transmisión
Reservorio
Humano, aves, suelo (principalmente contaminado con heces de paloma), vegetación (hojarasca).
Hospedadores
Humanos, animales domésticos, salvajes y de compañía como: equinos, bovinos, cánidos, caprinos, felinos, aves, etc.
Dosis Infectiva Mínima (DIM)
Se desconoce en la actualidad.
Supervivencia ambiental
Es capaz de sobrevivir durante varios años en suelos ricos en materia orgánica, sobre todo en heces de palomas, donde se multiplica rápidamente.
Formas de resistencia
En condiciones adversas forma esporas que pueden llegar a ser más infectivas que las células en forma de levadura.
Mecanismo de propagación y transmisión
La transmisión ocurre principalmente por medio de las esporas o células desecadas del hongo, que se encuentran presentes en el ambiente y penetran por vía respiratoria al interior del organismo. Rara vez se produce por inoculación accidental o por la penetración a través de heridas o lesiones.
No está demostrada la transmisión directa o de animal a persona. La transmisión de persona a persona es muy rara, se han descrito casos relacionados con trasplantes de órganos (8).
Vías de entrada
Respiratoria. Percutánea.
Distribución geográfica
Mundial.
Efectos sobre la salud
Grupo de riesgo
2A
(Ver Anexo II RD 664/1997 )Infección
Criptococosis pulmonar: infección que afecta principalmente a personas inmunodeprimidas, pudiendo estar acompañada de una enfermedad respiratoria, aunque la mayoría de las infecciones son asintomáticas. En personas inmunocompetentes puede causar síntomas respiratorios leves (dolor torácico pleurítico, disnea, febrícula, tos y expectoración en los casos más graves), y en individuos inmunodeprimidos puede extenderse a otros órganos (criptococosis diseminada), principalmente al sistema nervioso central (criptococosis cerebral: meningoencefalitis, meningitis criptocócica) y a la piel (criptococosis cutánea).
Criptococosis cutánea primaria: lesiones localizadas como pápulas, vesículas, úlceras, nódulos subcutáneos, celulitis, etc., como consecuencia de la inoculación accidental.
Efectos alérgicos (Ver Anexo II RD 664/1997 ) / (Ver Allergen )
Las esporas del hongo pueden desencadenar efectos alérgicos al ser inhaladas y depositarse en el sistema respiratorio.
Efectos tóxicos (Ver Anexo II RD 664/1997 )
No se han descrito
Efectos cancerígenos (Ver International Agency for Research On Cancer - IARC )
No se han descrito
Efectos en la maternidad
No se han descrito
Enfermedad
| CIE-10 | Nombre | Enfermedad de Declaración Obligatoria |
|---|---|---|
| B45 | Criptococosis | No |
Actividades laborales con riesgo
Clasificación Nacional de Actividades Económicas (CNAE)
| CNAE 2009 | Descripción |
|---|---|
| A0111 | Cultivo de cereales, distintos de arroz, leguminosas y oleaginosas |
| A0112 | Cultivo de arroz |
| A0113 | Cultivo de hortalizas, raíces y tubérculos |
| A0114 | Cultivo de caña de azúcar |
| A0116 | Cultivo de plantas para fibras textiles |
| A0122 | Cultivo de frutos tropicales y subtropicales |
| A0130 | Propagación de plantas |
| A0141 | Explotación de ganado bovino para la producción de leche |
| A0142 | Explotación de otro ganado bovino y búfalos |
| A0143 | Explotación de caballos y otros equinos |
| A0144 | Explotación de camellos y otros camélidos |
| A0145 | Explotación de ganado ovino y caprino |
| A0146 | Explotación de ganado porcino |
| A0147 | Avicultura |
| A0148 | Otras explotaciones de ganado |
| A0150 | Producción agrícola combinada con la producción ganadera |
| A0161 | Actividades de apoyo a la agricultura |
| A0162 | Actividades de apoyo a la ganadería |
| A0163 | Actividades de preparación posterior a la cosecha y tratamiento de semillas para reproducción |
| A0170 | Caza, captura de animales y servicios relacionados |
| B0510 | Extracción de antracita y hulla |
| B0520 | Extracción de lignito |
| B0710 | Extracción de minerales de hierro |
| B0721 | Extracción de minerales de uranio y torio |
| B0729 | Extracción de otros minerales metálicos no férreos |
| B0899 | Otras industrias extractivas n.c.o.p. |
| B0990 | Actividades de apoyo a otras industrias extractivas |
| C1011 | Procesado y conservación de carne, excepto volatería |
| C1310 | Preparación e hilado de fibras textiles |
| E3600 | Captación, depuración y distribución de agua |
| E3700 | Recogida y tratamiento de aguas residuales |
| E3811 | Recogida de residuos no peligrosos |
| F4211 | Construcción de carreteras y autopistas |
| F4212 | Construcción de vías férreas de superficie y subterráneas |
| F4213 | Construcción de puentes y túneles |
| F4221 | Construcción de redes para fluidos |
| F4291 | Obras hidráulicas |
| F4299 | Construcción de otros proyectos de ingeniería civil n.c.o.p. |
| F4312 | Preparación de terrenos |
| F4313 | Perforaciones y sondeos |
| F4322 | Fontanería, instalación de sistemas de calefacción y aire acondicionado |
| G4623 | Comercio al por mayor de animales vivos |
| N7500 | Actividades veterinarias |
| O8123 | Otras actividades de limpieza |
| O8130 | Actividades de jardinería |
| R8699 | Otras actividades sanitarias n.c.o.p. |
| S9122 | Actividades de sitios históricos y monumentos |
| S9141 | Actividades de los jardines botánicos y los parques zoológicos |
| S9311 | Gestión de instalaciones deportivas |
| S9329 | Actividades recreativas y de entretenimiento n.c.o.p. |
| T9630 | Pompas fúnebres y actividades relacionadas |
Clasificación Nacional de Ocupaciones (CNO)
| CNO 2011 | Descripción |
|---|---|
| 2130 | Veterinarios |
| 2421 | Biólogos, botánicos, zoólogos y afines |
| 2432 | Ingenieros en construcción y obra civil |
| 2454 | Ingenieros geógrafos y cartógrafos |
| 2462 | Ingenieros técnicos de obras públicas |
| 2483 | Ingenieros técnicos en topografía |
| 2821 | Sociólogos, geógrafos, antropólogos, arqueólogos y afines |
| 3122 | Técnicos en construcción |
| 3132 | Técnicos en instalaciones de tratamiento de residuos, de aguas y otros operadores en plantas similares |
| 3141 | Técnicos en ciencias biológicas (excepto en áreas sanitarias) |
| 3327 | Ayudantes de veterinaria |
| 5893 | Cuidadores de animales y adiestradores |
| 5992 | Bañistas-socorristas |
| 6110 | Trabajadores cualificados en actividades agrícolas (excepto en huertas, invernaderos, viveros y jardines) |
| 6120 | Trabajadores cualificados en huertas, invernaderos, viveros y jardines |
| 6201 | Trabajadores cualificados en actividades ganaderas de vacuno |
| 6202 | Trabajadores cualificados en actividades ganaderas de ovino y caprino |
| 6203 | Trabajadores cualificados en actividades ganaderas de porcino |
| 6205 | Trabajadores cualificados en la avicultura y la cunicultura |
| 6209 | Trabajadores cualificados en actividades ganaderas no clasificados bajo otros epígrafes |
| 7250 | Mecánicos-instaladores de refrigeración y climatización |
| 7618 | Artesanos en tejidos, cueros y materiales similares, preparadores de fibra y tejedores con telares artesanos o de tejidos de punto y afines |
| 7709 | Catadores y clasificadores de alimentos y bebidas |
| 7833 | Cortadores de tejidos, cuero, piel y otros materiales |
| 7893 | Clasificadores y probadores de productos (excepto alimentos, bebidas y tabaco) |
| 8155 | Operadores de máquinas para tratar pieles y cuero |
| 8193 | Operadores de máquinas de embalaje, embotellamiento y etiquetado |
| 8331 | Operadores de maquinaria de movimientos de tierras y equipos similares |
| 9229 | Otro personal de limpieza |
| 9443 | Barrenderos y afines |
| 9511 | Peones agrícolas (excepto en huertas, invernaderos, viveros y jardines) |
| 9512 | Peones agrícolas en huertas, invernaderos, viveros y jardines |
| 9520 | Peones ganaderos |
| 9530 | Peones agropecuarios |
| 9601 | Peones de obras públicas |
| 9602 | Peones de la construcción de edificios |
| 9603 | Peones de la minería, canteras y otras industrias extractivas |
| 9700 | Peones de las industrias manufactureras |
| 9811 | Peones del transporte de mercancías y descargadores |
Prevención y control
Desinfectantes
Alcohol etílico al 70%, hipoclorito sódico al 1%, clorhexidina al 0,5%, compuestos fenólicos, formaldehído, glutaraldehído, yodóforos.
Inactivación física
Por encima de 40ºC no se desarrolla y muere entre 55-60ºC.
Puede inactivarse con microondas, calor húmedo a 121ºC durante al menos 20 minutos, y calor seco a 170ºC durante al menos 2 horas.
Antimicrobianos
Anfotericina B, itraconazol, fluconazol, 5-fluorocitosina.
Vacunación
No disponible
Medidas preventivas generales
Orden y limpieza en el lugar de trabajo: limpieza y desinfección de instalaciones, equipos y herramientas.
Evitar la generación de polvo y bioaerosoles: utilizar métodos húmedos, métodos de aspiración o extracción localizada.
Buenas prácticas de higiene: lavado de manos, limpieza y desinfección de heridas, utilizar ropa de trabajo y equipos de protección individual.
Precauciones en centros sanitarios
En hospitales o centros sanitarios, adoptar las Precauciones Estándar.
EPI
Protección de las manos: guantes impermeables para manipular materiales, sustancias, pacientes o equipos que puedan estar contaminados.
Protección respiratoria: mascarillas autofiltrantes, al menos FFP2, o máscaras con filtros P2 en tareas que puedan generar polvo o bioaerosoles.
Protección ocular: gafas de protección de montura universal en caso de riesgo de contacto accidental mano/guante contaminado-ojo, o pantalla de protección facial (símbolo de marcado en montura: 3) en tareas que impliquen la generación de polvo, bioaerosoles o salpicaduras o gafa de protección de montura integral con hermeticidad frente a partículas (símbolo de marcado en montura: 4), en caso de riesgo de exposición a polvo.
Seguridad en laboratorio
Nivel de contención: 2
Los principales riesgos son la inhalación de bioaerosoles contaminados con las esporas o células desecadas del hongo y la inoculación accidental con instrumentos contaminados.
Las muestras o especímenes más peligrosos son el suelo, guano, o deyecciones de aves, cultivos del hongo, sangre, orina, líquido cefalorraquídeo y especímenes de la médula ósea, del cerebro, de los ojos, de las vías respiratorias, de la piel y de las membranas mucosas.
Se requieren las prácticas y la contención de un nivel 2 de bioseguridad, evitar el empleo de material cortante o punzante, utilizar cabina de seguridad biológica en aquellas operaciones que impliquen generación de bioaerosoles, proyecciones o salpicaduras y utilizar guantes impermeables en el caso de contacto con muestras contaminadas y animales afectados.
Bibliografía
- García, J. A., & Picazo, J. J. (2008). Compendio de microbiología clínica. Elsevier.
- Velagapudi, R., Hsueh, Y. P., Geunes-Boyer, S., Wright, J. R., & Heitman, J. (2009). Spores as infectious propagules of Cryptococcus neoformans. Infection and immunity, 77(10), 4345-4355. DOI: 10.1128/IAI.00542-09.
- Centers for Disease Control and Prevention (CDC). (2020). C. neoformans Infection. CDC: Fungal diseases.
- Institut National de Recherche et de Sécurité (INRS). (2023). Cryptococcus neoformans. BAse d'OBservation des Agents Biologiques (BAOBAB).
- Instituto Nacional de Seguridad y Salud en el Trabajo (INSST). Notas Técnicas de Prevención (NTP): 299, 376, 539, 700, 771 y 802.
- Public Health Agency of Canada. (2018). Cryptococcus neoformans. Pathogen Safety Data Sheets.
- Servicio Riojano de Salud. (2008). Precauciones de aislamiento en centros sanitarios.
- The Center for Food Security and Public Health (CFSPH). (2013). Cryptococcosis. CFSPH: Disease information.